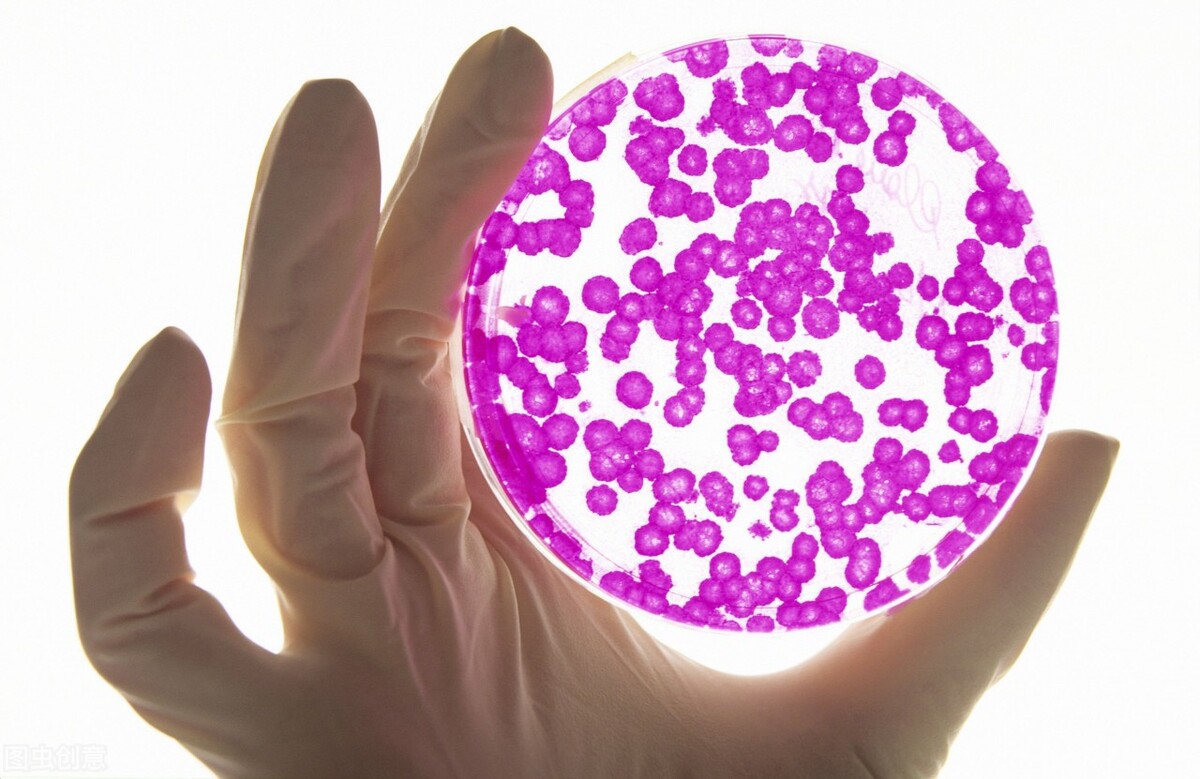
肺癌做基因检测要多少钱,肺癌基因检测医保报多少

肺癌治疗的药物进展迅速,在近20年来不断有抗癌新药问世,其中,针对不同基因异常的分子靶向药物,以及免疫治疗药物,都已被大量的基础和临床研究数据证实了其安全性和有效性,已经广泛的在中晚期肺癌病人中使用,并且显著延长了很多病人的寿命。随着这些新型抗癌药物的出现,同时在不断发展创新的,是针对肿瘤各种基因异常的检测技术。

在2000年之后的初期,第一种针对肺癌的靶向药物吉非替尼在国内开始使用,那时,尽管已经明确这种药物是针对EGFR基因突变而发挥作用的,但由于当时还没有较好的可以应用于临床的基因检测技术,所有使用这种药物的病人基本都属于“盲吃”,也就是提前不知道是否会有效,只能先吃一个月,根据复查结果来判断疗效和是否继续使用。随着分子检测技术逐渐发展,后来才开始能够使用手术或者活检的肿瘤标本进行EGFR基因的检测,根据检测结果,预测疗效,从而有针对性地选择合适的患者和药物。

后来,对各种肿瘤相关基因的了解越来越深入,更多的肺癌驱动基因异常被发现,更多的分子靶向药物,比如针对ALK和ROS1基因突变、HER2突变、c-MET突变等等的药物逐渐被研发出来。而且,随着这些分子靶向药物在临床使用的时间延长,耐药问题不可避免的出现,多个耐药基因突变位点被发现,并有二代、三代的各种靶向药物被设计制作出来,用于克服前代药物的耐药。这些情况,使得医生和病人在选择治疗药物时,对于基因检测的需求就变成了必要。

当前,针对肺癌患者的基因检测技术已经发展出多种,临床常用的包括针对蛋白表达的免疫组化染色技术,针对基因突变的ARMS PCR技术、Sanger法、微滴式数字PCR技术(dd PCR),针对基因融合和基因拷贝数检测的FISH技术,以及能够满足上述各种检测 要求的NGS基因测序技术等。这些检测技术,各有其优缺点,在选择的时候,要根据检测目的、所能够获得的标本的种类和数量,结合病情以及病人家庭的经济因素进行合理选择。

免疫组化染色技术、ARMS PCR技术、Sanger法和FISH技术都只能使用肿瘤组织标本进行检测,而不能对胸腹水及血液进行检测。其中,免疫组化染色的检测对象是特定的某种蛋白质的表达水平,在对肺癌进行诊断以及分型时使用,对于指导免疫治疗药物的选择最为重要,可以检测肺癌组织中PD-L1蛋白的表达水平如何,从而初步预测病人对免疫治疗的效果如何。ARMS PCR技术、Sanger法和FISH技术都是对基因突变或插入/缺失突变进行检测的方法,它们的共同优点是检测比较快速简便。但是,这几种方法有共同的缺点:(1)都只能检测目前已知的几个热点基因的异常,而无法发现新的或者少见的基因异常;(2)都只能对一个基因位点或者基因的一小段区域进行检测,所以一次检测获得的结果单一,效率相对低下;(3)检测的灵敏度比较低,也就是说,如果用于检测的肿瘤组织中异常基因的量比较低,或者标本中本身含有的癌细胞数量较少,可能会出现无法检出,而导致假阴性结果。
相较前几种方法,dd PCR和NGS技术存在比较大的优势。这两种方法可以对肿瘤组织标本以及液体标本(包括胸腹水、脑脊液、血液)都进行检测,而且灵敏度明显升高,而又以NGS技术的检测灵敏度和准确性最高。dd PCR依然只能对一个基因突变位点或者基因融合位点进行检测,但NGS技术又被称为“高通量测序”,可以一次性检测数百上千个基因,并且深度很高,极低水平的基因异常也可以检测出来,而且能否发现未知的、罕见的基因突变。因此,在病人经济情况允许的前提下,更推荐选择NGS技术进行肿瘤基因检测,以给医生提供尽可能全面的信息,从而更好的指导治疗并判断预后。缺点是,NGS技术操作过程复杂且价格昂贵,需要有资质的专业实验室才可以开展。

对于肺癌患者及其家庭来说,罹患此症已经是个沉重的打击,面对众多医学专业术语,面对各种检查和治疗方法药物,都会感到无所适从。选择正规、专业的医院和医生,结合自身的情况,有针对性的接受个体化的治疗,才是每位患者的正确选择。

更多健康信息,请关注武宁医生头条号!